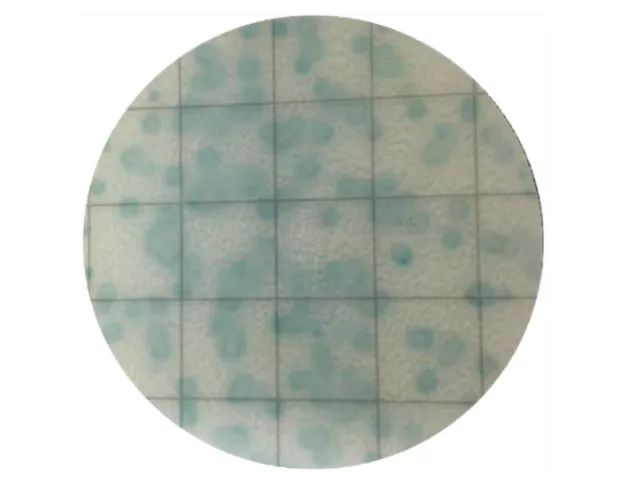

- 3M 微生物檢測片同等品
- 顯色明顯,直接計數菌落顏色

仙人掌桿菌 Bacillus cereus
培養時間:36°C / 18-24 hours菌落判讀:藍綠色團狀菌落
最佳計數範圍:10 ~ 100 CFU
包裝規格:25片/包
儲藏溫度:2~8℃

1. 測試樣品的pH值過高或過低(落在PH6-8較佳)容易影響測試結果的準確性。
2. 掀起上膜時,不要接觸培養基的微生物培養區。
3. 測試片與上膜應朝上疊放,培養過程中不超過20片。
4. 測試片應避光,須遠離實驗室紫外線、陽光直射和螢光燈。
5. 不要使用被污染的測試片。
6. 測試片使用後請進行高壓滅菌,然後按照相關廢棄物管理進行處理。
7. 測試片可能會出現一些針狀黑點,屬於正常現象,不影響對目標菌株的判讀。
日澤微生物快檢片解決方案列表

目標/適用基質 |
產品名稱/廠牌 |
培養溫度/時間 |
判讀結果 |
驗證 |
---|---|---|---|---|
總生菌數 AC |
35±1℃ |
所有紅色菌落 |
MicroVal 2015LR52 |
|
食品/水/環境/落菌 |
JNC |
24±2小時 |
||
總生菌 Aerobic Count |
36±1℃ |
所有紅色菌落 | AOAC PTM 032103 | |
食品/水/環境/落菌 |
PerkinElmer |
48±1小時 |
||
大腸桿菌群 CC |
35±1℃ |
藍綠/藍色菌落 |
MicroVal 2017LR70 |
|
食品/水/環境/落菌 |
JNC |
24±2小時 |
||
大腸桿菌和大腸桿菌群 EC |
35±1℃ |
大腸桿菌: |
MicroVal 2017LR71 |
|
食品/水/環境/落菌 |
JNC |
24±2小時 |
||
大腸桿菌和大腸桿菌群 E. coli/ Coliform |
36±1℃ |
大腸桿菌: 周圍有氣泡的藍色菌落 大腸桿菌群: 周圍有氣泡的藍色或紅色菌落 |
AOAC PTM 102103 | |
食品/水/環境/落菌 |
PerkinElmer |
24±2小時 |
||
腸桿菌科 EB |
37℃ |
具有黃色暈環的紅色菌落 | - | |
食品/水/環境/落菌 |
JNC |
24小時 |
||
腸桿菌科 |
36±1℃ |
具有黃色暈環的紅色菌落 |
AOAC PTM 112101 |
|
食品/水/環境/落菌 |
PerkinElmer |
18-24小時 |
||
金黃色葡萄球菌 SA |
35±1℃ |
藍/水藍色菌落 |
MicroVal 2015LR56 |
|
食品/水/環境/落菌 |
JNC |
24±2小時 |
||
金黃色葡萄球菌 |
36±1℃ |
粉紅色菌落 | AOAC PTM 122102 | |
食品/水/環境/落菌 |
PerkinElmer |
24±2小時 |
||
黴菌和酵母菌 YM |
25±1℃ |
酵母菌:紅色圓形菌落 |
MicroVal 2015LR51 |
|
食品/水/環境/落菌 |
JNC |
48-72小時 |
||
酵母菌和黴菌 |
28±1℃ |
酵母菌: 小顆且邊緣平整的藍綠色菌落 黴菌: 大顆且擴散型的藍綠色菌落 隨著培養時間,菌落可能伴隨黑色或紫色等其他顏色 |
AOAC PTM 122101 | |
食品/水/環境/落菌 |
PerkinElmer |
48-60小時 |
||
沙門氏菌 SALMONELLA |
35±1℃ |
水藍色菌落 |
- |
|
食品/水/環境/落菌 |
JNC |
24±2小時 |
||
環境李斯特菌 |
36±1℃ |
藍綠色菌落 |
- |
|
環境 |
PerkinElmer |
18-24小時 |
||
乳酸菌 |
36±1℃ |
帶有黃色光暈的紅色及藍綠色菌落 | - | |
食品/水/環境/落菌 |
PerkinElmer |
48±1小時 |
||
仙人掌桿菌 |
36±1℃ |
藍綠色團狀菌落 |
- |
|
食品/水/環境/落菌 |
PerkinElmer |
18-24小時 |
產業應用
食品 / 飲品 / 餐飲業 / 化妝品 / 保健食品 / 研究檢驗 / 衛生管理